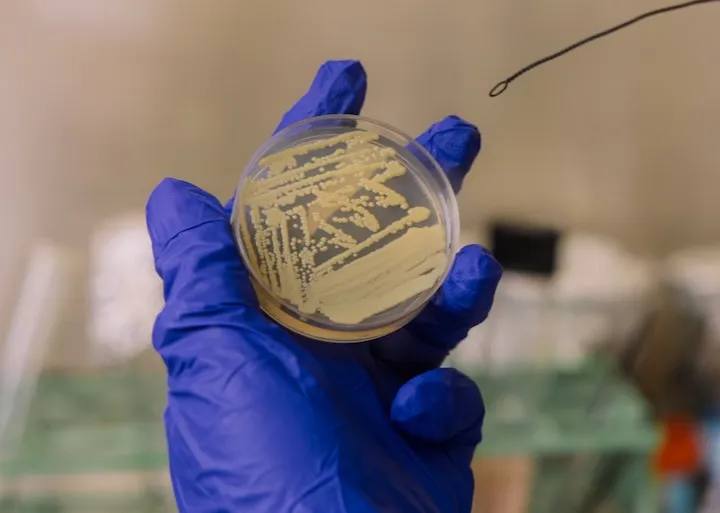

صحة
ناسا تكتشف بكتيريا تتظاهر بالموت للنجاة
وجد العلماء نوعًا نادرًا من البكتيريا داخل غرف التعقيم في ناسا قادرًا على الدخول في سبات تام يشبه الموت ليهرب من الحرارة والمواد القاتلة للميكروبات. وعند عودة الظروف المناسبة، تستيقظ الخلايا وتعود للنمو.
تكمن خطورة الاكتشاف في أن هذه البكتيريا قد تُخفي نفسها داخل المركبات الفضائية دون أن تُكتشف، ما قد يؤدي إلى تلويث كواكب مثل المريخ ويؤثر على نتائج البحث عن حياة خارج الأرض.
الدراسة تؤكد أن حتى أكثر البيئات تعقيمًا يمكن أن تحتوي ميكروبات خفية، مما يجعل تطوير طرق فحص أدق ضرورة علمية مهمة